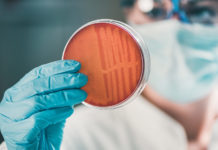
Antibiotics: Blind optimism is dangerous

Tag: bacteria
Antibiotics: Blind optimism is dangerous
The increased frequency with which doctors are encountering antibiotic-resistant bacteria is worrying. And it could affect an already precarious medical field—cancer treatment.